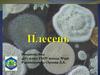
Плесень (плесневые грибы)

Similar presentations:
Плесень: друг или враг
1. Плесень друг или враг
Ученика 5 «в» классаМБОУ школы №133
Харитонова Александра
2. Мы в этой работе узнаем плесень для человека друг или враг.
Другвраг
3. ОПРЕДЕЛЕНИЕ
ОПРЕДЕЛЕНИЕ
Плесень – это микроскопический
гриб, который образует налёт,
вызывая порчу продуктов. Её
относят к классу грибов, которых
насчитывается свыше 100 000
видов. Размножается плесень с
помощью
спор,
которые
прорастают очень быстро и
образуют подобные нитям клетки,
называемые
гифами.
Гифы,
переплетаясь
между
собой,
образуют пушистый клубок нитей
– мицелий. Это и есть то, что мы
называем плесенью.
4. Полезные свойства плесени
Вспомните такое открытие, как пенициллин! В 1928 году английскиймикробиолог Александер Флеминг случайн обнаружил антибактериальное
свойство зеленой лесени.
Эта плесень, названная цылин, пениспособна
убивать бактерии, но безвредна для человека и
животных. Это
открытие положило начало
производству пенициллина,
который считается
«самым действенным средством в медицине». В
1945 году Флеминг и его коллеги Хоуард Флори и
Эрнст Чейн удостоились за свой труд Нобелевской
премии в области медицины. Плесень также открыла
двери в восхитительный
мир вкуса. Взять, к
примеру, сыр.
Знаете ли вы, что такие сорта сыра, как бри, камамбер, голубой датский
сыр, горгонцола, рокфор и стилтон обязаны своим особенным вкусом
некоторым видам плесени рода пенициллиум? То же самое можно сказать
и о соевом соусе и пиве. Кроме того, плесень применяется в виноделии.
Ягоды винограда, на которых образовалось нужное количество плесени,
собирают в определенное время и используют в производстве элитных
десертных вин.
5. Когда плесень становится врагом?
Об опасных свойствах некоторых видовплесени известно уже давно. В VI веке до н. э.
ассирийцы
использовали
древний
вид
биологического оружия - спорынью, с помощью
которой они отравляли воду в колодцах своих
врагов. Но опасна не сама плесень, а миллионы
спор,
выделяемых
ею
в
окружающее
пространство и вдыхаемых нами вместе с
воздухом.
Попадая
в
дыхательную
и
кровеносную систему, споры
могут
провоцировать ряд заболеваний. Кроме того,
при размножении плесень выделяет летучие
органические соединения, ответственные за
специфический запах и чрезвычайно вредные
для здоровья.
Вот краткий перечень заболеваний,
связанных с плесенью: мигрень, насморк, отит,
бронхит,
ринит,
бронхиальная
астма,
нарушения, микотоксикоз. Иногда у людей со
сниженным иммунитетом возможны поражения
внутренних
органов.
Все
перечисленные
заболевания носят хронический характер
течения и вызывают трудности при лечении.
6. Интересные факты о плесени
Плесеньраспространяется
по
воздуху в виде микроскопических спор.
Лучшими условиями для плесени являются
влага и тепло (температура плюс 20 – 30
градусов).
Она не любит чистоту и
сухой воздух!
Плесень
распространяется
по
воздуху в виде микроскопических спор. При
попадании на сырую
поверхность
она
прорастает тончайшими нитями (мицелий).
Считается, что идеальные условия
для пявления и распространения плесени –
температура плюс 20 0С и относительная
влажность воздуха выше 95%. Плохой
воздухообмен поддерживает рост грибков.
Плесень активно размножается на многих
материалах и покрытиях, используемых
внутри
помещений,
включая
бетон,
штукатурку,
дерево,
пластики,
резину,
тканевую основу линолеума, окрашенные
поверхности, ковровые покрытия, книги и т.д.
7. ЗАКЛЮЧЕНИЕ.
•Для благоприятного появления и развитияплесени
необходимы
определённые
условия. Такими благоприятными условиями
являются
повышенная
влажность,
отсутствие прямого доступа кислорода и
тепло.
•Плесень появляется раньше на тех
продуктах, в которых содержится много
влаги.
•Плесень вызывает гниение продуктов.
•Продукты, заражённые плесенью, нельзя
использовать в пищу, они вызывают
отравление и различные заболевания.
•Необходимо проветривать помещения и не
допускать повышенной влажности, чтобы в
них не развивалась плесень.







 biology
biology